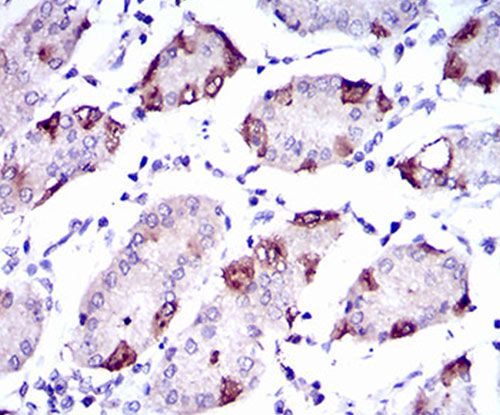
Fig5: Immunohistochemical analysis of paraffin-embedded human stomach tissue using anti-SLC27A5 antibody. Counter stained with hematoxylin.

-
Product Name
Anti-SLC27A5 antibody
- Documents
-
Description
Mouse monoclonal antibody to SLC27A5
-
Tested applications
WB, IHC-P
-
Species reactivity
Human, Mouse
-
Alternative names
BAL antibody; ACSB antibody; BACS antibody; FATP5 antibody; ACSVL6 antibody; FACVL3 antibody; FATP-5 antibody; VLACSR antibody; VLCSH2 antibody; VLCS-H2 antibody
-
Isotype
Mouse IgG1
-
Preparation
This antigen of this antibody was recombinant protein
-
Clonality
Monoclonal
-
Formulation
Liquid, 1*TBS (pH7.4), 1%BSA, Preservative: 0.05% Sodium Azide.
-
Storage instructions
Store at +4℃ after thawing. Aliquot store at -20℃ or -80℃. Avoid repeated freeze / thaw cycles.
-
Applications
WB: 1:500-1:1,000
IHC-P: 1:100-1:200
-
Validations

Fig1: Western blot analysis of SLC27A5 on human SLC27A5 recombinant protein using anti-SLC27A5 antibody at 1/1,000 dilution.

Fig2: Western blot analysis of SLC27A5 on HEK293 (1) and SLC27A5-hIgGFc transfected HEK293 (2) cell lysate using anti-SLC27A5 antibody at 1/1,000 dilution.

Fig3: Western blot analysis of SLC27A5 on 3T3L1 (1) and NIH3T3 (2) cell lysate using anti-SLC27A5 antibody at 1/1,000 dilution.

Fig4: Immunohistochemical analysis of paraffin-embedded human liver cancer tissue using anti-SLC27A5 antibody. Counter stained with hematoxylin.
Fig5: Immunohistochemical analysis of paraffin-embedded human stomach tissue using anti-SLC27A5 antibody. Counter stained with hematoxylin.
- Background
-
References
- Przybylla S et al. Analysis of the Bile Salt Export Pump (ABCB11) Interactome Employing Complementary Approaches. PLoS One 11:e0159778 (2016).
- Auinger A et al. A promoter polymorphism in the liver-specific fatty acid transport protein 5 is associated with features of the metabolic syndrome and steatosis. Horm Metab Res 42(12):854-9 (2010).
Related Products / Services
Please note: All products are "FOR RESEARCH USE ONLY AND ARE NOT INTENDED FOR DIAGNOSTIC OR THERAPEUTIC USE"
